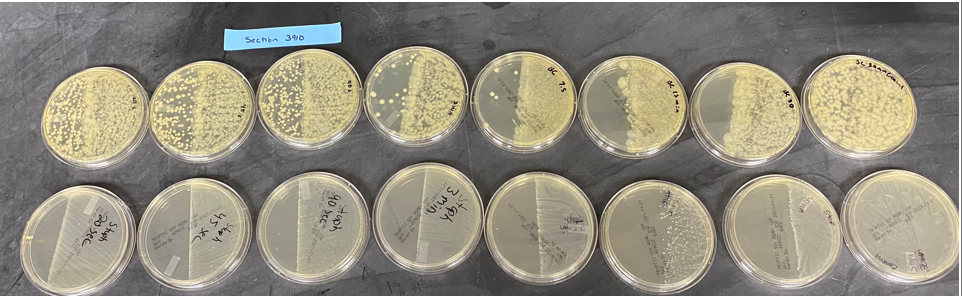
<p>Look at the the image, TOP is B. Cereus, BOTTOM is S. Epidermis. </p><p>Going left to right the time increases, right side of each plate was covered. </p><p>Questions: What do these results say about B. Cereus? </p>

Lab 8
1/19
Earn XP
Description and Tags
These flashcards cover key concepts related to bacterial identification techniques, antibiotic sensitivity testing, transformation, and biochemical assays.
Name | Mastery | Learn | Test | Matching | Spaced | Call with Kai |
|---|
No analytics yet
Send a link to your students to track their progress
20 Terms
What is the zone of inhibition in an antibiotic sensitivity test?
area around antibiotic disk where bacteria does not grow in millimeters
What does a zone of inhibition indicate if there is no growth around the antibiotic disk?
It is highly effective against the bacteria tested, suggesting susceptibility.
Define Minimum Inhibitory Concentration (MIC).
lowest concentration of an antimicrobial that prevents the visible growth of bacteria.
What is Minimum Bactericidal Concentration (MBC)?
lowest concentration of an antibacterial agent required to kill a bacterium over a specific time.

Look at the the image, TOP is Cereus , BOTTOM is S. Epidermis.
Going left to right the time exposed to UV increases, right side of each plate was covered.
Question: What do these results say about S. Epidermis?
S. Epidermis lacks the ability to produce endospores, indicated by the lack of colonies under any UV light exposure
Look at the the image, TOP is B. Cereus, BOTTOM is S. Epidermis.
Going left to right the time increases, right side of each plate was covered.
Questions: What do these results say about B. Cereus?
B. Cereus has the ability to produce endospores, indicated by the presence of colonies under UV light exposure, however longer exposure to reduced the effectiveness
What is the role of CaCl2 in bacterial transformation?
CaCl2 neutralizes the negative charges between the cell and the plasmid, allowing DNA entry into the cell.
How do competent cells acquire new DNA?
Competent cells can take up free DNA from their environment and incorporate it into their genome through transformation.
What is the purpose of the Sulfide-Indole-Motility (SIM) medium?
SIM medium is used to differentiate bacteria based on sulfur reduction, indole production, and motility.
What is the pH indicator used in Simmon's Citrate Agar (SCA)?
Citric acid use by Gram - bacteria, indicated by color change to blue
What does a yellow color in Triple Sugar Iron (TSI) agar indicate?
A yellow color indicates that sugar fermentation has occurred, resulting in an acidic pH.
What does the pH indicator used in Urea Agar tell us?
That the enzyme urease is present, increasing the pH, turning the substance a bright pink in turn
What type of infections can Enterobacteriaceae cause?
They can cause diarrhea, sepsis, pneumonia, urinary tract infections, and other serious conditions.
What distinguishes Chromagar from other differential media?
allows for rapid identification of bacterial species based on the color of the colonies.
What does a pink colony on Chromagar indicate?
bacteria expressing the B-galactosidase enzyme.
What is the significance of endospore producing bacteria in UV light exposure?
Endospore producing bacteria require longer UV exposure times before showing a decrease in growth due to their protective nature.
In the context of bacterial conjugation, what is a sex pilus?
structure used by bacteria to transfer genetic material from one cell to another during conjugation.
What are the applications of bacterial transformation?
Applications include DNA cloning, protein production, genetic engineering, and genetic exchange.
What is transformation?
Horizontal gene transfer where cells pick up DNA from their environment and incorporate into their genome
Describe how transformation occurs
DNA will bind to protein on cell surface, one strand is digested and the other is taken inside.